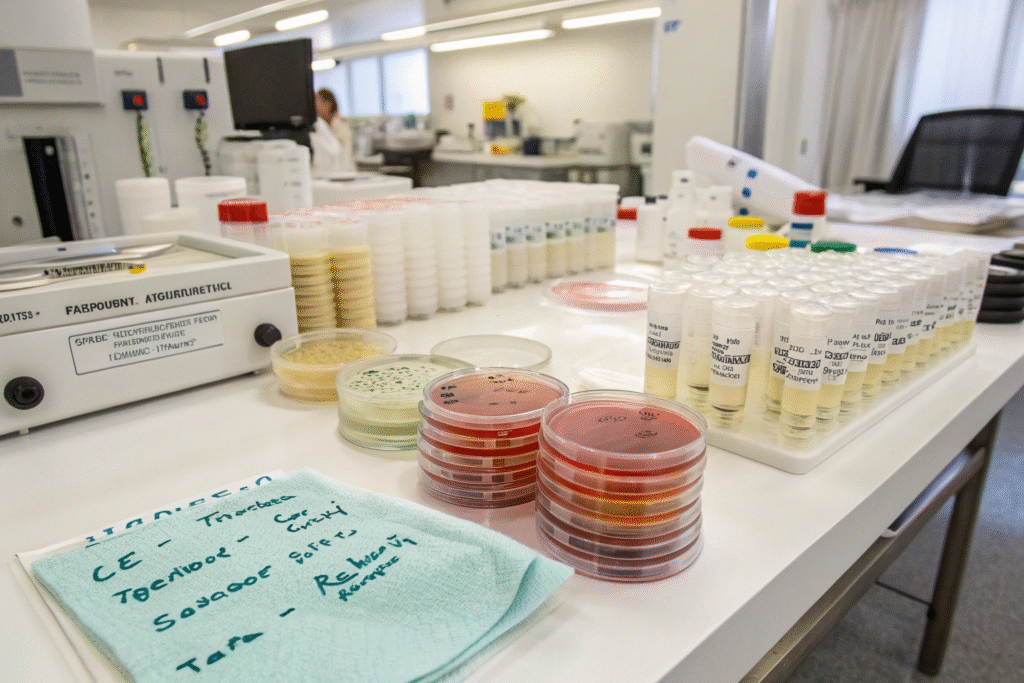

In the post-pandemic era, hotel guests are more concerned about hygiene than ever before. For hospitality buyers and fabric importers, offering bedding solutions with anti-microbial protection is no longer optional—it’s expected. But sourcing the right material, with verified anti-microbial efficacy and soft, luxurious feel, is a challenge.
To source anti-microbial hotel bedding fabric, look for textile mills offering tested silver-ion treatments, OEKO-TEX® or EPA certifications, and proven durability through industrial wash cycles.
In this guide, we’ll cover what makes a bedding fabric truly anti-microbial, which finishes work best, and how to find reliable, compliant manufacturers for your hotel projects.
What Makes Bedding Fabric Truly Anti-Microbial?
Anti-microbial bedding fabric is designed to inhibit the growth of harmful microorganisms such as bacteria, fungi, and mold. Unlike antibacterial coatings that only target a narrow range of bacteria, anti-microbial treatments offer broader protection—ideal for high-turnover hotel environments.
A truly anti-microbial hotel fabric is lab-tested, skin-safe, and effective through dozens of commercial laundry cycles.
What Types of Anti-Microbial Treatments Are Used?
Common technologies include:
- Silver ion (Ag+) finishes – disrupt bacterial DNA and prevent odor
- Zinc oxide – naturally anti-fungal and UV-protective
- Quaternary ammonium compounds (quats) – effective but less eco-friendly
- Aloe vera and chitosan blends – plant-based, used in wellness resorts
For example, HeiQ Viroblock and Sanitized® Silver are widely used for premium hospitality-grade fabrics.
How Can You Verify Anti-Microbial Claims?
Request third-party test reports using:
- AATCC 100 – Quantitative bacterial reduction
- ISO 20743 – Dynamic contact test
- JIS L 1902 – Common in Asian labs
Suppliers should provide at least 99.9% bacterial reduction data and mention wash durability (e.g., >50 cycles). See examples via SGS or Intertek.
Which Fabrics Work Best for Hotel Bedding Applications?
Not all fabrics are created equal when it comes to hotel bedding. Beyond antimicrobial properties, the textile must also feel soft, resist wrinkling, and withstand industrial washing. Cotton remains king—but blends often offer better performance.
The best bedding fabrics combine softness, moisture management, and antimicrobial functionality—often through fiber integration or durable topical finishes.

What Are the Most Popular Base Fabrics?
- 100% long-staple cotton (sateen or percale) – luxury touch, breathable
- Tencel™ Lyocell – eco-friendly, hypoallergenic, natural bacteria resistance
- Bamboo Rayon – silky hand-feel and odor control
- Poly-cotton blends – more durable, wrinkle-resistant
- Recycled polyester – used in budget or bulk hospitality projects
Tencel™ has natural moisture-wicking and is OEKO-TEX® certified, as listed by Lenzing and verified by Textile Exchange.
How Do You Ensure Performance After Washing?
Many suppliers claim anti-microbial properties, but they disappear after 10–15 washes. Ask your supplier for:
- Wash test results (EN ISO 6330)
- Colorfastness and shrinkage reports
- Residual bacteria testing post-wash
At Fumao Fabric, our anti-microbial bedding options are tested up to 50 wash cycles and include enzyme-washed finishes for better pilling resistance and hand-feel. Certificates and lab results are available upon request.
How to Find Reliable Anti-Microbial Bedding Suppliers?
Finding the right partner for anti-microbial bedding means filtering through marketing fluff and focusing on traceability, testing, and logistical reliability.
The most trustworthy suppliers offer lab-tested, certificate-backed, and customizable fabric solutions with ongoing support for hospitality buyers.

What Certifications Should You Look For?
- OEKO-TEX® Standard 100 – ensures skin safety and chemical compliance
- REACH or Prop 65 compliance – for U.S. and EU chemical standards
- ISO 9001 & ISO 14001 – for quality and environmental management
- EPA Registration (U.S.) or BPR (EU) – for chemical treatment regulation
Suppliers can be cross-verified via OEKO-TEX Directory or bluesign® System Partner List.
How Does Fumao Ensure Fabric Quality and Compliance?
At Fumao, we work with:
- CNAS-certified labs for AATCC 100 and ISO 20743 testing
- Global dyeing partners using silver and aloe-based antimicrobial tech
- Internal QC that includes random batch tests and QR code tracking
- Clients in Europe, Southeast Asia, and the U.S. hospitality industry
We provide swatch kits, wash test results, and customized GSM and weave adjustments. MOQ as low as 300m per color available for boutique hotels.
What Should You Consider for Bulk Hotel Bedding Orders?
Bulk ordering hotel bedding fabric isn’t just about choosing the right finish—it’s about consistency, delivery timelines, and compliance with regional hygiene regulations.
Successful sourcing depends on proper finishing, labeling, and logistics planning—especially for multi-site hotel chains or global distributors.

What Are the Key Logistics and Compliance Factors?
- Labeling: antimicrobial claims must match test data
- Customs: some countries regulate chemical treatments (e.g., U.S. EPA, EU REACH)
- Finishing: calendaring, brushing, enzyme washing all affect feel and performance
- Packaging: plastic-free, moisture-controlled, labeled by lot
At Fumao, we support anti-microbial bulk programs with layered packaging, container-level barcoding, and documentation for customs entry and client compliance audits.
Can You Customize GSM, Weave, or Finishes?
Yes. We offer:
- Cotton sateen 60s/40s, 300TC, 450TC, and 600TC
- Custom finishing (enzyme wash, anti-pilling, softener)
- Aloe + silver compound options
- Jacquard and dobby patterns for boutique or high-end hotels
Clients can receive pre-approved lab dips and QA swatches before production. Lead time for anti-microbial finishing: 25–30 days depending on order volume.
Conclusion
In hospitality, every detail matters—and that includes bedding fabric. Sourcing anti-microbial hotel bedding is not only a hygiene upgrade but a brand statement. From silver-ion technology to eco-certified finishes, the right fabric elevates both guest satisfaction and operational efficiency.
At Shanghai Fumao, we offer verified anti-microbial fabric solutions for global hotel clients—delivered with full test documentation, customization, and expert sourcing support.
To request swatches, test reports, or quotation for your next hospitality bedding order, contact our Business Director Elaine at elaine@fumaoclothing.com today.